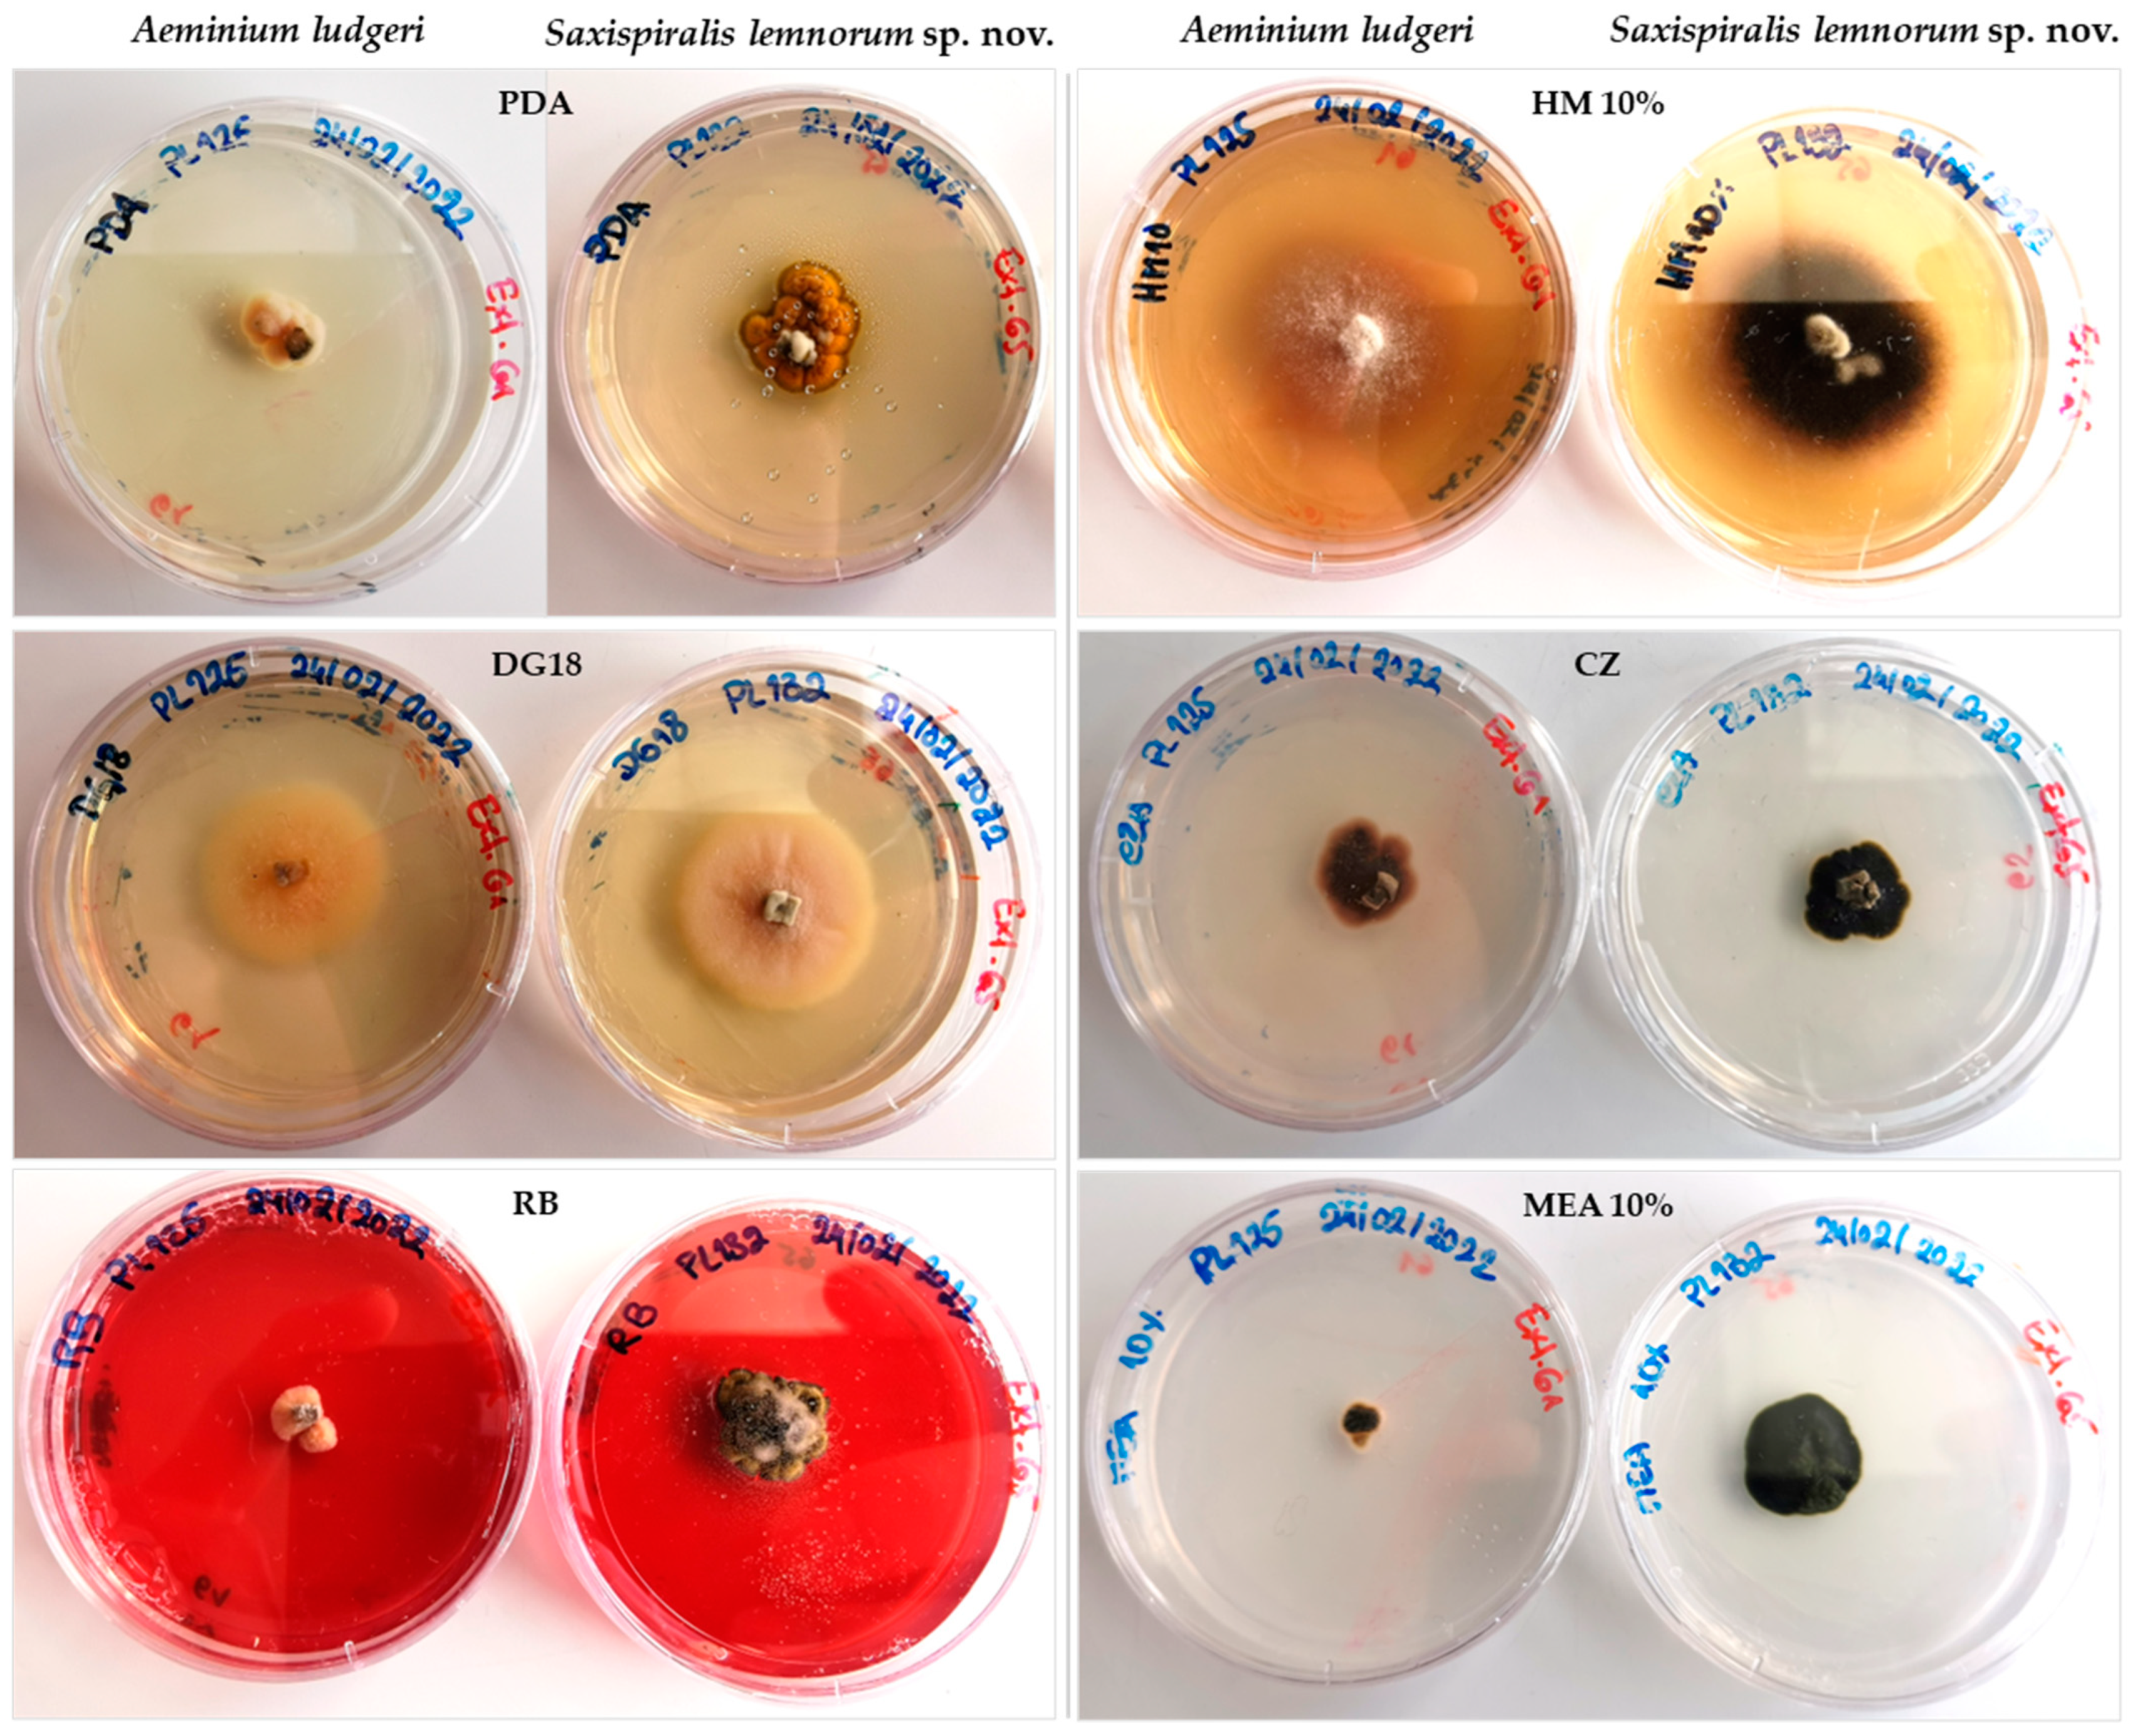
Jof 09 00916 g0a1
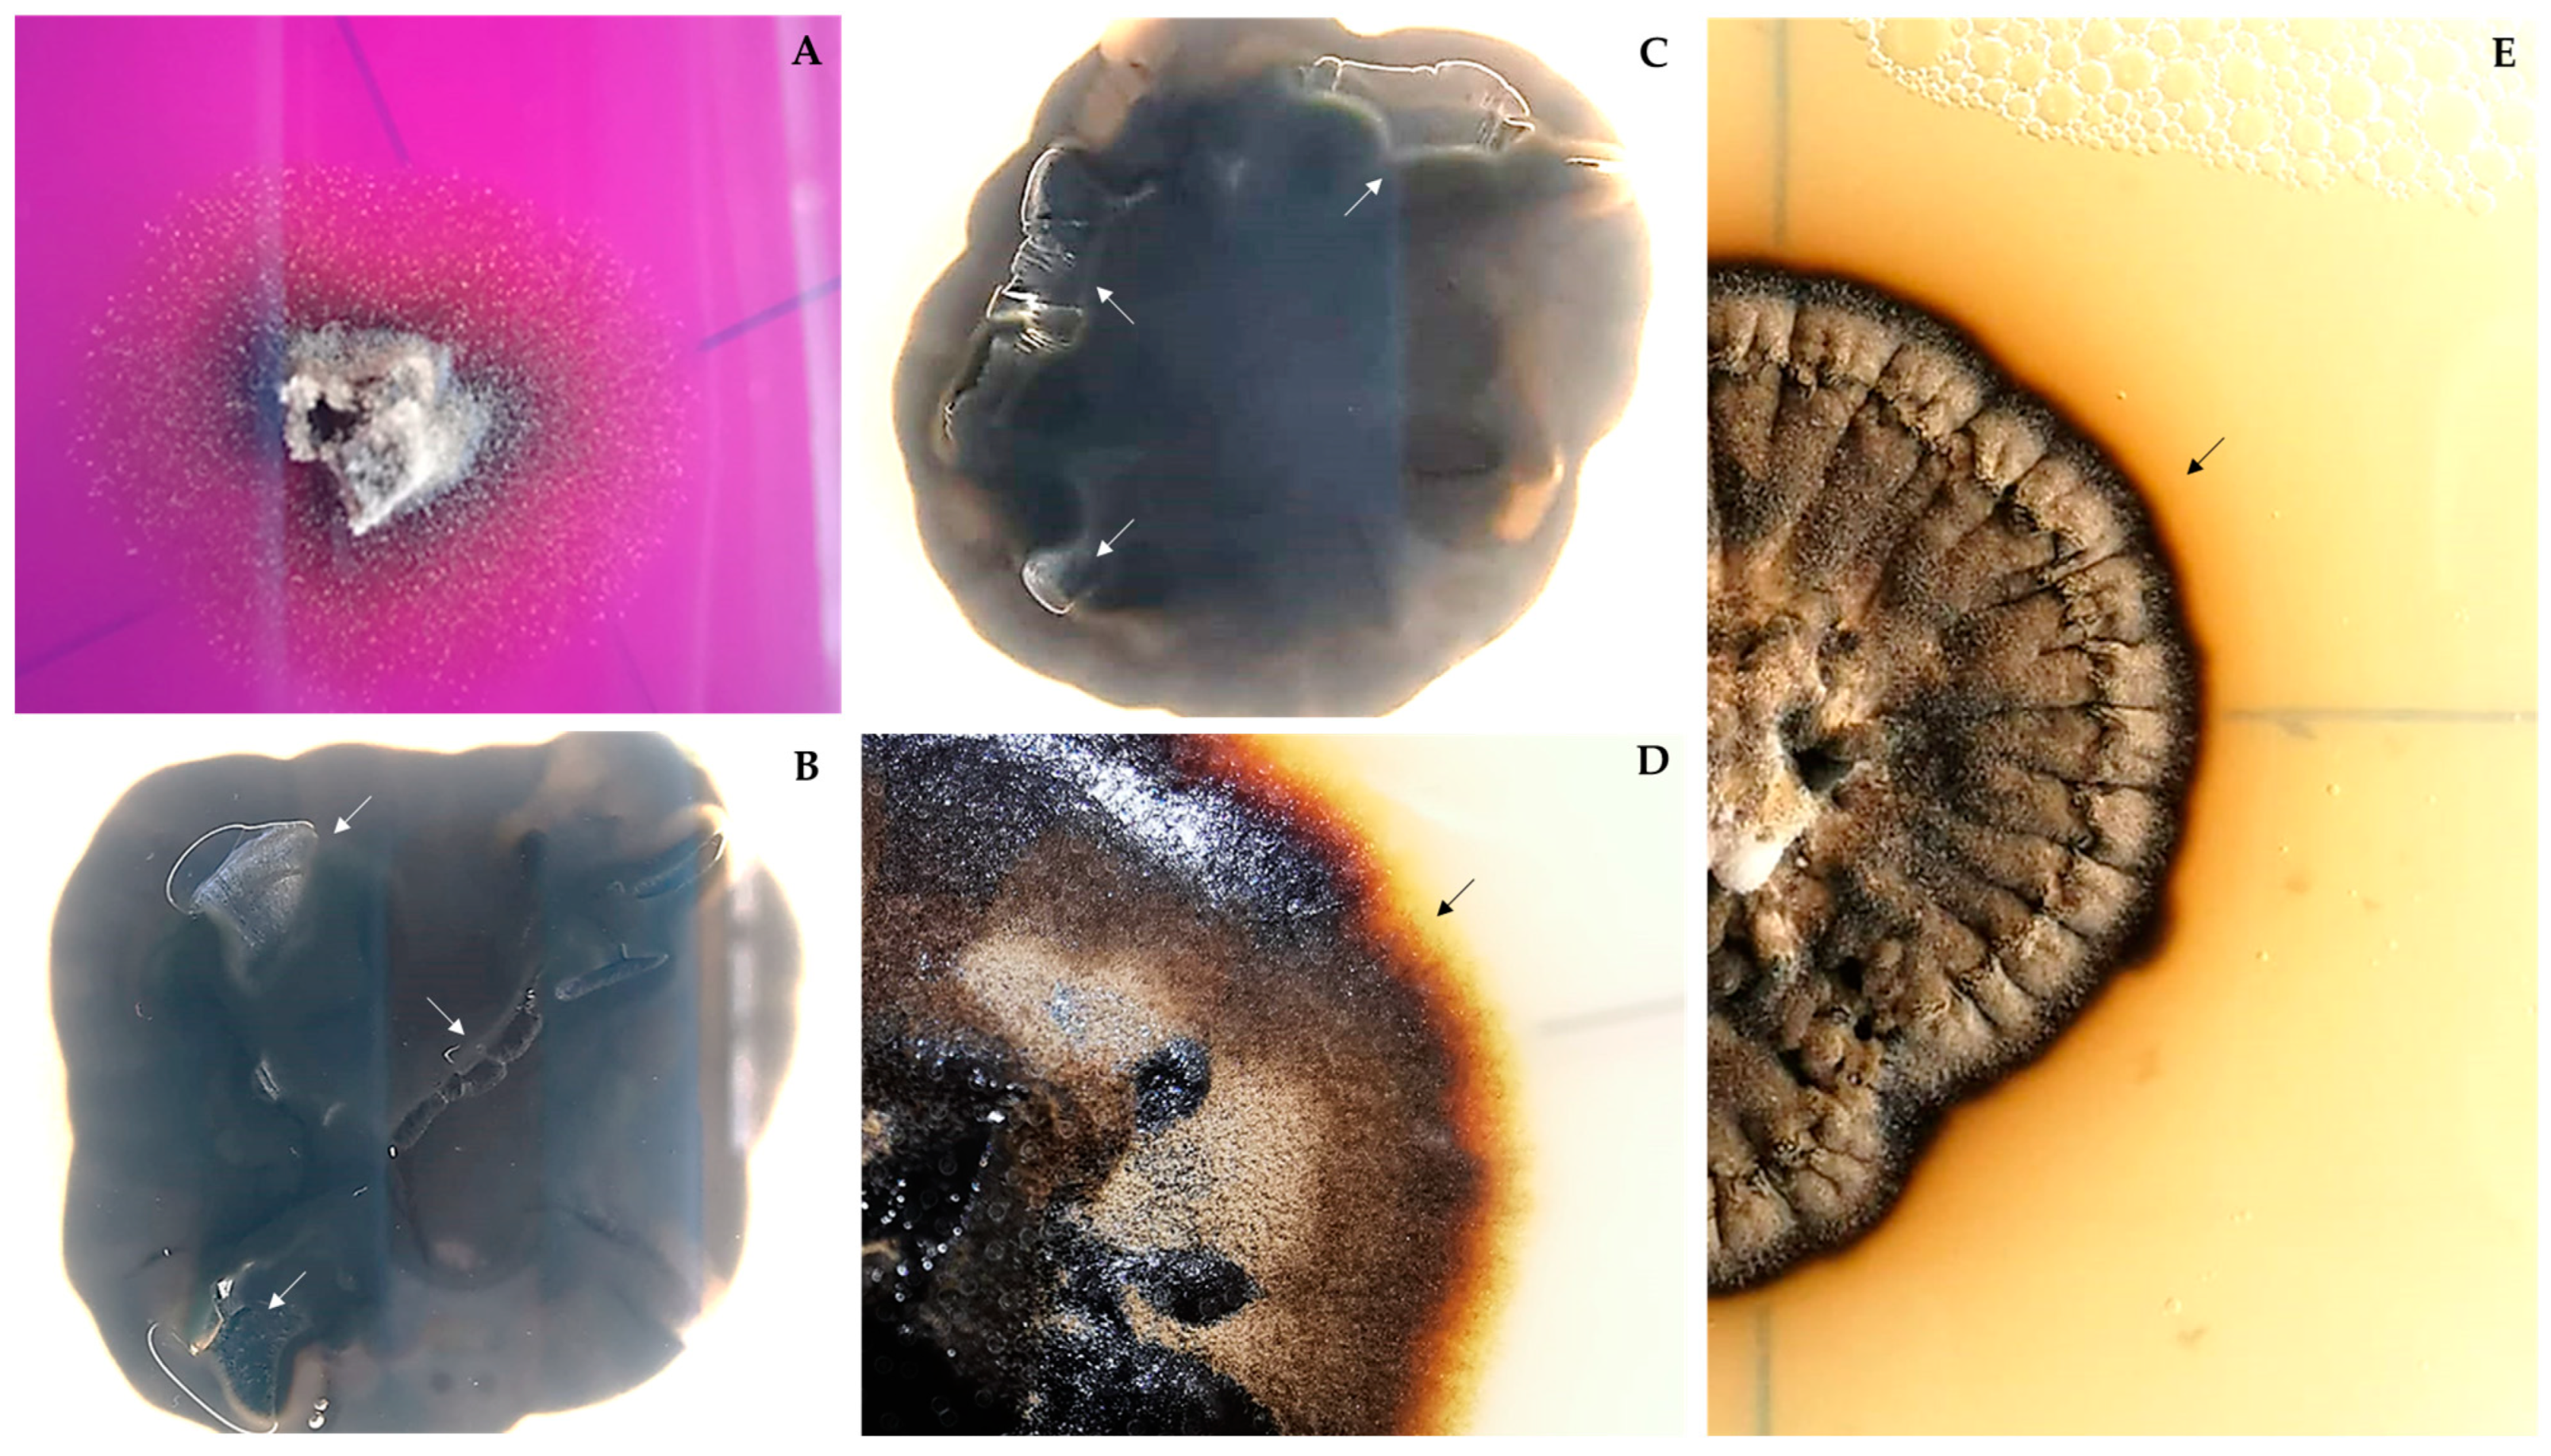
Jof 09 00916 g0a3

Expanding the Microcolonial Black Fungi Aeminiaceae Family: Saxispiralis lemnorum gen. et sp. nov. (Mycosphaerellales), Isolated from Deteriorated Limestone in the Lemos Pantheon, Portugal
Abstract
:1. Introduction
2. Materials and Methods
2.1. Site Description, Sample Collection, and Fungal Isolation
2.2. DNA Extraction, PCR Amplification and Sequencing
2.3. Phylogenetic Analysis
2.4. Morphological Characterization
2.5. Physiological Characterization
2.5.1. Temperature Preferences
2.5.2. NaCl Tolerance
2.5.3. pH Tolerance
2.5.4. UV Tolerance
2.5.5. Heat and Cold Stress Tolerance
2.6. Deteriorative Potential Analysis
3. Results and Discussion
3.1. Phylogenetic Analysis
3.2. Taxonomy and Morphological Characterization
3.3. Physiological Characterization
3.4. Deteriorative Potential
4. Conclusions
Supplementary Materials
Author Contributions
Funding
Institutional Review Board Statement
Informed Consent Statement
Data Availability Statement
Acknowledgments
Conflicts of Interest
Appendix A

References
- Beraldi-Campesi, H. Early life on land and the first terrestrial ecosystems. Ecol. Processes. 2013, 2, 1. [Google Scholar] [CrossRef]
- Gorbushina, A.A.; Krumbein, W.E.; Volkmann, M. Rock surfaces as life indicators: New ways to demonstrate life and traces of former life. Astrobiology 2002, 2, 203–213. [Google Scholar] [CrossRef] [PubMed]
- Gorbushina, A.A. Life on the rocks. Environ. Microbiol. 2007, 9, 1613–1631. [Google Scholar] [CrossRef] [PubMed]
- Hoppert, M.; Flies, C.; Pohl, W.; Gunzl, B.; Schneider, J. Colonization strategies of lithobiontic microorganisms on carbonate rocks. Environ. Geol. 2004, 46, 421–428. [Google Scholar] [CrossRef]
- Tiano, P. Biodegradation of cultural heritage: Decay mechanisms and control methods. In Seminar Article; New University of Lisbon, Department of Conservation and Restoration: Campolide, Lisbon, 2002; pp. 7–12. [Google Scholar]
- Garcia-Vallès, M.; Vendrell-Saz, M.; Molera, J.; Blazquez, F. Interaction of rock and atmosphere: Patinas on Mediterranean monuments. Environ. Geol. 1998, 36, 137–149. [Google Scholar] [CrossRef]
- Saiz-Jimenez, C. Deposition of anthropogenic compounds on monuments and their effect on airborne microorganisms. Aerobiologia 1995, 11, 161–175. [Google Scholar] [CrossRef]
- Golubic, S.; Perkins, R.D.; Lukas, K.J. Boring Microorganisms and Microborings in Carbonate Substrates. In The Study of Trace Fossils; Frey, R.W., Ed.; Springer: Berlin/Heidelberg, Germany, 1975; pp. 229–259. [Google Scholar] [CrossRef]
- Selbmann, L.; de Hoog, G.S.; Zucconi, L.; Isola, D.; Ruisi, S.; Gerrits van den Ende, A.H.G.; Ruibal, C.; De Leo, F.; Urzì, C.; Onofri, S. Drought meets acid: Three new genera in a dothidealean clade of extremotolerant fungi. Stud. Mycol. 2008, 61, 1–20. [Google Scholar] [CrossRef]
- Selbmann, L.; De Hoog, G.S.; Mazzaglia, A.; Friedmann, E.I.; Onofri, S. Fungi at the edge of life: Cryptoendolithic black fungi from Antarctic desert. Stud. Mycol. 2005, 51, 1–32. [Google Scholar]
- Hirsch, P.; Mevs, U.; Kroppenstedt, R.M.; Schumann, P.; Stackebrandt, E. Cryptoendolithic actinomycetes from Antarctic rock samples: Micromonospora endolithica sp. nov. and two isolates related to Micromonospora coerulea Jensen 1932. Syst. Appl. Microbiol. 2004, 27, 166–174. [Google Scholar] [CrossRef]
- Friedmann, E.I. Endolithic microorganisms in the Antarctic cold desert. Science 1982, 215, 1045–1053. [Google Scholar] [CrossRef]
- Staley, J.T.; Palmer, F.; Adams, J.B. Microcolonial fungi: Common inhabitants on desert rocks? Science 1982, 215, 1093–1095. [Google Scholar] [CrossRef]
- Krumbein, W.E.; Jens, K. Biogenic rock varnishes of the Negev desert (Israel) an ecological study of iron and manganese transformation by cyanobacteria and fungi. Oecologia 1981, 50, 25–38. [Google Scholar] [CrossRef] [PubMed]
- Selbmann, L.; Egidi, E.; Isola, D.; Onofri, S.; Zucconi, Z.; de Hoog, G.S.; Chinaglia, S.; Testa, L.; Tosi, S.; Balestrazzi, A.; et al. Biodiversity, evolution and adaptation of fungi in extreme environments. Plant Biosyst. 2013, 147, 237–246. [Google Scholar] [CrossRef]
- Yurlova, N.A.; de Hoog, G.S.; Fedorova, L.G. The influence of ortho- and para-diphenoloxidase substrates on pigment formation in black yeast-like fungi. Stud. Mycol. 2008, 61, 39–49. [Google Scholar] [CrossRef] [PubMed]
- Butinar, L.; Sonjak, S.; Zalar, P.; Plemenitaš, A.; Gunde-Cimerman, N. Melanized halophilic fungi are eukaryotic members of microbial communities in hypersaline waters of solar salterns. Bot. Mar. 2005, 48, 73–79. [Google Scholar] [CrossRef]
- Dakal, T.C.; Cameotra, S.S. Microbially induced deterioration of architectural heritages: Routes and mechanisms involved. Environ. Sci. Eur. 2012, 24, 36. [Google Scholar] [CrossRef]
- Scheerer, S.; Ortega-Morales, O.; Gaylarde, C. Chapter 5 Microbial Deterioration of Stone Monuments–An Updated Overview. Adv. Appl. Microbiol. 2009, 66, 97–139. [Google Scholar] [CrossRef]
- Sterflinger, K. Fungi as geologic agents. Geomicrobiol. J. 2000, 17, 97–124. [Google Scholar] [CrossRef]
- Gadd, G.M. Fungi, Rocks, and Minerals. Elements 2017, 3, 171–176. [Google Scholar] [CrossRef]
- Gadd, G.M. Geomycology: Biogeochemical transformations of rocks, minerals, metals and radionuclides by Fungi, Bioweathering and Bioremediation. Mycol. Res. 2007, 111, 3–49. [Google Scholar] [CrossRef]
- Warscheid, T.; Braams, J. Biodeterioration of stone: A review. Int. Biodeterior. Biodegrad. 2000, 46, 343–368. [Google Scholar] [CrossRef]
- Gadd, G.M. Geomicrobiology of the built environment. Nat. Microbiol. 2017, 2, 16275. [Google Scholar] [CrossRef] [PubMed]
- Sterflinger, K.; Piñar, G. Microbial deterioration of cultural heritage and works of ar –Tilting at windmills? Appl. Microbiol. Biotechnol. 2013, 97, 9637–9646. [Google Scholar] [CrossRef] [PubMed]
- Sterflinger, K. Fungi: Their role in deterioration of cultural heritage. Fungal Biol. Rev. 2010, 24, 47–55. [Google Scholar] [CrossRef]
- Liu, B.; Fu, R.; Wu, B.; Liu, X.; Xiang, M. Rock-inhabiting fungi: Terminology, diversity, evolution and adaptation mechanisms. Mycology 2021, 13, 1–31. [Google Scholar] [CrossRef]
- de Hoog, G.S.; McGinnis, M.R. Ascomycetous black yeasts. In The Expanding Realm of Yeast-Like Fungi; de Hoog, G.S., Smith, M.T., Weijman, A.C.M., Eds.; Elsevier: Amsterdam, The Netherlands, 1987; pp. 187–199. [Google Scholar]
- Gueidan, C.; Villasenor, C.R.; de Hoog, G.S.; Gorbushina, A.A.; Untereiner, W.A. A rock-inhabiting ancestor for mutualistic and pathogen-rich fungal lineages. Stud. Mycol. 2008, 61, 111–119. [Google Scholar] [CrossRef]
- Gueidan, C.; Ruibal, C.; de Hoog, G.S.; Schneider, H. Rock-inhabiting fungi originated during periods of dry climate in the late Devonian and middle Triassic. Fungal Biol. 2011, 115, 987–996. [Google Scholar] [CrossRef]
- Gueidan, C.; Aptroot, A.; Caceres, M.E.D.; Badali, H.; Stenroos, S. A reappraisal of orders and families within the subclass Chaetothyriomycetidae (Eurotiomycetes, Ascomycota). Mycol. Prog. 2014, 13, 1027–1039. [Google Scholar] [CrossRef]
- Ametrano, C.G.; Muggia, L.; Grube, M. Extremotolerant Black Fungi from Rocks and Lichens. In Fungi in Extreme Environments: Ecological Role and Biotechnological Significance; Grube, M., Ed.; Springer: Cham, Switzerland, 2019; pp. 119–143. [Google Scholar] [CrossRef]
- Abdollahzadeh, J.; Groenewald, J.Z.; Coetzee, M.P.A.; Wingfield, M.J.; Crous, P.W. Evolution of lifestyles in Capnodiales. Stud. Mycol. 2020, 95, 381–414. [Google Scholar] [CrossRef]
- De Leo, F.; Marchetta, A.; Urzì, C. Black Fungi on Stone-Built Heritage: Current Knowledge and Future Outlook. Appl. Sci. 2022, 12, 3969. [Google Scholar] [CrossRef]
- Palmer, F.E.; Emery, D.R.; Stemmler, J.; Staley, J.T. Survival and growth of microcolonial rock fungi as affected by temperature and humidity. New Phytol. 1987, 107, 155–162. [Google Scholar] [CrossRef]
- Urzì, C.; De Leo, F.; de Hoog, S.; Sterflinger, K. Recent advances in the molecular biology and ecophysiology of meristematic stone-inhabiting fungi. In Of Microbes and Art: The Role of Microbial Communities in the Degradation and Protection of Cultural Heritage; Ciferri, O., Tiano, P., Mastromei, G., Eds.; Springer: Boston, MA, USA, 2000; pp. 3–19. [Google Scholar] [CrossRef]
- Sterflinger, K. Black yeasts and meristematic fungi: Ecology, diversity and identification. In The Yeast Handbook, Biodiversity and Ecophysiology of Yeasts; Péter, G., Rosa, C., Eds.; Springer: Berlin/Heidelberg, Germany, 2006; pp. 501–514. [Google Scholar] [CrossRef]
- Selbmann, L.; de Hoog, G.S.; Zucconi, L.; Isola, D.; Onofri, S. Black Yeasts in Cold Habitats. In Cold-Adapted Yeasts; Buzzini, P., Margesin, R., Eds.; Springer: Berlin/Heidelberg, Germany, 2014; pp. 137–189. [Google Scholar] [CrossRef]
- Selbmann, L.; Zucconi, L.; Isola, D.; Onofri, S. Rock black fungi: Excellence in the extremes, from the Antarctic to space. Curr. Genet. 2015, 61, 335–345. [Google Scholar] [CrossRef]
- Tesei, D. Black Fungi Research: Out-of-This-World Implications. Encyclopedia 2022, 2, 212–229. [Google Scholar] [CrossRef]
- Gorbushina, A.A.; Whitehead, K.; Dornieden, T.; Niesse, A.; Schulte, A.; Hedges, J.I. Black fungal colonies as units of survival: Hyphal mycosporines synthesized by rock-dwelling microcolonial fungi. Can. J. Bot. 2003, 81, 131–138. [Google Scholar] [CrossRef]
- Gorbushina, A.A.; Kotlova, E.R.; Sherstneva, O.A. Cellular responses of microcolonial rock fungi to long-term desiccation and subsequent rehydration. Stud. Mycol. 2008, 61, 91–97. [Google Scholar] [CrossRef] [PubMed]
- Zakharova, K.; Tesei, D.; Marzban, G.; Dijksterhuis, J.; Wyatt, T.; Sterflinger, K. Microcolonial fungi on rocks: A life in constant drought? Mycopathologia 2013, 175, 537–547. [Google Scholar] [CrossRef]
- Wollenzien, U.; de Hoog, G.S.; Krumbein, W.E.; Uijthof, J.M.J. Sarcinomyces petricola, a new microcolonial fungus from marble in the Mediterranean basin. Antonie Van Leeuwenhoek J. Microbiol. 1997, 71, 281–288. [Google Scholar] [CrossRef]
- Sterflinger, K.; de Baere, R.; de Hoog, G.S.; de Wachter, R.; Krumbein, W.E.; Haase, G. Coniosporium perforans and C. apollinis, two new rock-inhabiting fungi isolated from marble in the Sanctuary of Delos (Cyclades, Greece). Antonie Van Leeuwenhoek J. Microbiol. 1997, 72, 349–363. [Google Scholar] [CrossRef] [PubMed]
- De Leo, F.; Urzì, C.; de Hoog, G.S. Two Coniosporium species from rock surfaces. Stud. Mycol. 1999, 43, 70–79. [Google Scholar]
- De Leo, F.; Urzì, C.; de Hoog, G. A new meristematic fungus, Pseudotaeniolina globosa. Antonie Van Leeuwenhoek J. Microbiol. 2003, 83, 351–360. [Google Scholar] [CrossRef]
- Sert, H.B.; Sümbül, H.; Sterflinger, K. A new species of Capnobotryella from monument surfaces. Mycol. Res. 2007, 111, 1235–1241. [Google Scholar] [CrossRef]
- Sert, H.B.; Sümbül, H.; Sterflinger, K. Microcolonial fungi from antique marbles in Perge/Side/Termessos (Antalya/Turkey). Antonie Van Leeuwenhoek J. Microbiol. 2007, 91, 217–227. [Google Scholar] [CrossRef]
- Sert, H.B.; Sümbül, H.; Sterflinger, K. Sarcinomyces sideticae, a new black yeast from historical marble monuments in Side (Antalya, Turkey). Bot. J. Linn. Soc. 2007, 154, 373–380. [Google Scholar] [CrossRef]
- Sert, H.B.; Sterflinger, K. A new Coniosporium species from historical marble monuments. Mycol. Prog. 2010, 9, 353–359. [Google Scholar] [CrossRef]
- Onofri, S.; Anastasi, A.; Del Frate, G.; Di Piazza, S.; Garnero, N.; Guglielminetti, M.; Isola, D.; Panno, L.; Ripa, C.; Selbmann, L.; et al. Biodiversity of rock, beach and water fungi in Italy. Plant Biosyst. 2011, 145, 978–987. [Google Scholar] [CrossRef]
- Sert, H.B.; Sümbül, H.; Sterflinger, K. Two new species of Capnobotryella from historical monuments. Mycol. Prog. 2011, 10, 333–339. [Google Scholar] [CrossRef]
- Martin-Sanchez, P.M.; Nováková, A.; Bastian, F.; Alabouvette, C.; Saiz-Jimenez, C. Two new species of the genus Ochroconis, O. lascauxensis and O. anomala isolated from black stains in Lascaux Cave, France. Fungal Biol. 2012, 116, 574–589. [Google Scholar] [CrossRef]
- Zucconi, L.; Gagliardi, M.; Isola, D.; Onofri, S.; Andaloro, M.C.; Pelosi, C.; Pogliani, P.; Selbmann, L. Biodeterioration agents dwelling in or on the wall paintings of the Holy Saviour’s cave (Vallerano, Italy). Int. Biodeterior. Biodegrad. 2012, 70, 40–46. [Google Scholar] [CrossRef]
- Isola, D.; Zucconi, L.; Onofri, S.; Caneva, G.; de Hoog, G.S.; Selbmann, L. Extremotolerant rock inhabiting black fungi from Italian monumental sites. Fungal Divers. 2016, 76, 75–96. [Google Scholar] [CrossRef]
- Trovão, J.; Tiago, I.; Soares, F.; Paiva, D.S.; Mesquita, N.; Coelho, C.; Catarino, L.; Gil, F.; Portugal, A. Description of Aeminiaceae fam. nov., Aeminium gen. nov. and Aeminium ludgeri sp. nov. (Capnodiales), isolated from a biodeteriorated art-piece in the old cathedral of Coimbra, Portugal. MycoKeys 2019, 45, 57–73. [Google Scholar] [CrossRef]
- Onofri, S.; Zucconi, L.; Isola, D.; Selbmann, L. Rock-inhabiting fungi and their role in deterioration of stone monuments in the Mediterranean area. Plant Biosyst. 2014, 148, 384–391. [Google Scholar] [CrossRef]
- Isola, D.; Bartoli, F.; Meloni, P.; Caneva, G.; Zucconi, L. Black Fungi and Stone Heritage Conservation: Ecological and Metabolic Assays for Evaluating Colonization Potential and Responses to Traditional Biocides. Appl. Sci. 2022, 12, 2038. [Google Scholar] [CrossRef]
- Sterflinger, K.; Krumbein, W.E. Dematiaceous fungi as a major agent of biopitting for Mediterranean marbles and limestones. Geomicrobiol. 1997, 14, 219–230. [Google Scholar] [CrossRef]
- Lombardozzi, V.; Castrignanò, T.; D’Antonio, M.; Casanova Municchia, A.; Caneva, C. An interactive database for an ecological analysis of stone biopitting. Int. Biodeterior. Biodegrad. 2012, 73, 8–15. [Google Scholar] [CrossRef]
- Paiva, D.S.; Fernandes, L.; Trovão, J.; Mesquita, N.; Tiago, I.; Portugal, A. Uncovering the Fungal Diversity Colonizing Limestone Walls of a Forgotten Monument in the Central Region of Portugal by High-Throughput Sequencing and Culture-Based Methods. Appl. Sci. 2022, 12, 10650. [Google Scholar] [CrossRef]
- Paiva, D.S.; Fernandes, L.; Pereira, E.; Trovão, J.; Mesquita, N.; Tiago, I.; Portugal, A. Exploring Differences in Culturable Fungal Diversity Using Standard Freezing Incubation—A Case Study in the Limestones of Lemos Pantheon (Portugal). J. Fungi 2023, 9, 501. [Google Scholar] [CrossRef]
- Igreja Paroquial de Trofa/Igreja de São Salvador e Panteão dos Lemos. Available online: http://www.monumentos.gov.pt/Site/APP_PagesUser/SIPA.aspx?id=1042 (accessed on 29 January 2023).
- Pinheiro, A.C.; Mesquita, N.; Trovão, J.; Soares, F.; Tiago, I.; Coelho, C.; Carvalho, H.P.; Gil, F.; Catarino, L.; Piñar, G.; et al. Limestone biodeterioration: A review on the portuguese cultural heritage scenario. J. Cult. Herit. 2019, 36, 275–285. [Google Scholar] [CrossRef]
- Miller, A.Z.; Leal, N.; Laiz, L.; Candelera, R.; Silva, M.A.; Dionisio, A.; Macedo, M.F.; Sáiz-Jiménez, C. Primary bioreceptivity of limestones used in southern European monuments. Geol. Soc. Lond. Spec. Publ. 2010, 331, 79–92. [Google Scholar] [CrossRef]
- White, T.; Bruns, T.; Lee, S.; Taylor, J. Amplification and direct sequencing of fungal ribosomal RNA genes for phylogenetics, In PCR Protocols: A Guide to Methods and Applications; Innis, M., Gelfand, D., Shinsky, J., White, T., Eds.; Academic Press: Cambridge, MA, USA, 1990; pp. 315–322. [Google Scholar]
- Gardes, M.; Bruns, T.D. ITS primers with enhanced specificity for basidiomycetes-application to the identification of mycor-rhizae and rusts. Mol. Ecol. 1993, 2, 113–118. [Google Scholar] [CrossRef] [PubMed]
- Vilgalys, R.; Hester, M. Rapid Genetic Identification and Mapping of Enzymatically Amplified Ribosomal DNA from Several Cryptococcus Species. J. Bacteriol. 1990, 172, 4238–4246. [Google Scholar] [CrossRef]
- Crous, P.W.; Schoch, C.L.; Hyde, K.D.; Wood, A.R.; Gueidan, C.; de Hoog, G.S.; Groenewald, J.Z. Phylogenetic Lineages in the Capnodiales. Stud. Mycol. 2009, 64, 17–47. [Google Scholar] [CrossRef]
- Liu, Y.J.; Whelen, S.; Hall, B.D. Phylogenetic relationships among Ascomycetes: Evidence from an RNA polymerase II subunit. Mol. Biol. Evol. 1999, 16, 1799–1808. [Google Scholar] [CrossRef] [PubMed]
- Quaedvlieg, W.; Kema, G.H.J.; Groenewald, J.Z.; Verkley, G.J.M.; Seifbarghi, S.; Razavi, M.; Mirzadi Gohari, A.; Mehrabi, R.; Crous, P.W. Zymoseptoria gen. nov.: A new genus to accommodate Septoria-like species occurring on graminicolous hosts. Persoonia 2011, 26, 57–69. [Google Scholar] [CrossRef] [PubMed]
- Altschul, S.F.; Madden, T.L.; Schäffer, A.A.; Zhang, J.; Zhang, Z.; Miller, W.; Lipman, D.J. Gapped BLAST and PSI-BLAST: A new generation of protein database search programs. Nucleic Acids Res. 1997, 25, 3389–3402. [Google Scholar] [CrossRef]
- Vázquez-Nion, D.; Rodríguez-Castro, J.; López-Rodríguez, M.C.; Fernández-Silva, I.; Prieto, B. Subaerial biofilms on granitic historic buildings: Microbial diversity and development of phototrophic multi-species cultures. Biofouling 2016, 32, 657–669. [Google Scholar] [CrossRef] [PubMed]
- Katoh, K.; Standley, D.M. MAFFT multiple sequence alignment software version 7: Improvements in performance and usability. Mol. Biol. Evol. 2013, 30, 772–780. [Google Scholar] [CrossRef] [PubMed]
- Okonechnikov, K.; Golosova, O.; Fursov, M. UGENE team Unipro UGENE: A unified bioinformatics toolkit. Bioinformatics 2012, 28, 1166–1167. [Google Scholar] [CrossRef] [PubMed]
- Gouy, M.; Guindon, S.; Gascuel, O. SeaView version 4: A multiplatform graphical user interface for sequence alignment and phylogenetic tree building. Mol. Biol. Evol. 2010, 27, 221–224. [Google Scholar] [CrossRef]
- Nylander, J.A.A. MrModeltest v2 Program Distributed by the Author; Evolutionary Biology Centre, Uppsala University: Uppsala, Sweden, 2004. [Google Scholar]
- Edler, D.; Klein, J.; Antonelli, A.; Silvestro, D. RaxmlGUI 2.0: A Graphical Interface and Toolkit for Phylogenetic Analyses Using RAxML. Methods Ecol. Evol. 2021, 12, 373–377. [Google Scholar]
- Ronquist, F.; Teslenko, M.; van der Mark, P.; Ayres, D.L.; Darling, A.; Höhna, S.; Larget, B.; Liu, L.; Suchard, M.A.; Huelsenbeck, J.P. MrBayes 3.2: Efficient bayesian phylogenetic inference and model choice across a large model space. Syst. Biol. 2012, 61, 539–542. [Google Scholar] [CrossRef]
- Rambaut, A.; Drummond, A.J. Tracer v 1.4. 2007. Available online: https://beast.bio.ed.ac.uk/Tracer (accessed on 24 April 2023).
- Rambaut, A.; Drummond, A.J. FigTree: Tree Figure Drawing Tool, Version 1.2.2. 2008. Available online: http://tree.bio.ed.ac.uk/software/figtree/ (accessed on 24 April 2023).
- Nirenberg, H.I. A simplified method for identifying Fusarium spp. occurring on wheat. Can. J. Bot. 1981, 59, 1599–1609. [Google Scholar] [CrossRef]
- Sterflinger, K. Temperature and NaCl- tolerance of rock-inhabiting meristematic fungi. Antonie Van Leeuwenhoek J. Microbiol. 1998, 74, 271–281. [Google Scholar] [CrossRef] [PubMed]
- Rizk, S.M.; Magdy, M.; De Leo, F.; Werner, O.; Rashed, M.A.-S.; Ros, R.M.; Urzì, C. A New Extremotolerant Ecotype of the Fungus Pseudotaeniolina globose Isolated from Djoser Pyramid, Memphis Necropolis, Egypt. J. Fungi 2021, 7, 104. [Google Scholar] [CrossRef] [PubMed]
- Tiago, I.; Chung, A.P.; Veríssimo, A. Bacterial Diversity in a Nonsaline Alkaline Environment: Heterotrophic Aerobic Populations. Appl. Environ. Microbiol. 2004, 70, 7378–7387. [Google Scholar] [CrossRef]
- Albertano, P.; Urzì, C. Structural Interactions among Epilithic Cyanobacteria and Heterotrophic Microorganisms in Roman Hypogea. Microb. Ecol. 1999, 38, 244–252. [Google Scholar] [CrossRef]
- Trovão, J.; Portugal, A. Current Knowledge on the Fungal Degradation Abilities Profiled through Biodeteriorative Plate Essays. Appl. Sci. 2021, 11, 4196. [Google Scholar] [CrossRef]
- Guggiari, M.; Bloque, R.; Aragno, M.; Verrecchia, E.; Job, D.; Junier, P. Experimental calcium-oxalate crystal production and dissolution by selected woodrot fungi. Int. Biodeterior. Biodegrad. 2011, 65, 803–809. [Google Scholar] [CrossRef]
- Boquet, E.; Boronat, A.; Ramos-Cormenzana, A. Production of Calcite (Calcium Carbonate) Crystals by Soil Bacteria Is a General Phenomenon. Nature 1973, 246, 527–529. [Google Scholar] [CrossRef]
- Samson, R.A.; Houbraken, J.; Thrane, U.; Frisvad, J.C.; Andersen, B. Food and Indoor Fungi, 2nd ed.; CBS-KNAW Fungal Biodiversity Centre: Utrecht, The Netherlands, 2010. [Google Scholar]
- Wijayawardene, N.; Hyde, K.D.; Dai, D.; Sánchez-García, M.; Goto, B.; Saxena, R.; Erdoğdu, M.; Selçuk, F.; Rajeshkumar, K.T.; Aptroot, A.; et al. Outline of Fungi and fungus-like taxa–2021. Mycosphere 2022, 13, 53–453. [Google Scholar] [CrossRef]
- Crous, P.W.; Schumacher, R.K.; Akulov, A.; Thangavel, R.; Hernández-Restrepo, M.; Carnegie, A.J.; Cheewangkoon, R.; Wingfield, M.J.; Summerell, B.A.; Quaedvlieg, W.; et al. New and Interesting Fungi. 2. Fungal Syst. Evol. 2019, 3, 57–134. [Google Scholar] [CrossRef]
- Czachura, P.; Owczarek-Kościelniak, M.; Piątek, M. Salinomyces polonicus: A moderately halophilic kin of the most extremely halotolerant fungus Hortaea werneckii. Fungal Biol. 2021, 125, 459–468. [Google Scholar] [CrossRef] [PubMed]
- Savković, Ž.; Unković, N.; Stupar, M.; Franković, M.; Jovanović, M.; Erić, S.; Šarić, K.; Stanković, S.; Dimkić, I.; Vukojević, J.; et al. Diversity and biodeteriorative potential of fungal dwellers on ancient stone stela. Int. Biodeterior. Biodegrad. 2016, 115, 212–223. [Google Scholar] [CrossRef]
- Unković, N.; Dimkić, I.; Stupar, M.; Stanković, S.; Vukojević, J.; Ljaljević Grbić, M. Biodegradative potential of fungal isolates from sacral ambient: in vitro study as risk assessment implication for the conservation of wall paintings. PLoS ONE 2018, 13, e0190922. [Google Scholar] [CrossRef]
- De Leo, F.; Antonelli, F.; Pietrini, A.M.; Ricci, S.; Urzì, C. Study of the euendolithic activity of black meristematic fungi isolated from a marble statue in the Quirinale Palace’s Gardens in Rome, Italy. Facies 2019, 65, 18. [Google Scholar] [CrossRef]
- Burford, E.P.; Hillier, S.; Gadd, G.M. Biomineralization of Fungal Hyphae with Calcite (CaCO3) and Calcium Oxalate Mono- and Dihydrate in Carboniferous Limestone Microcosms. Geomicrobiol. J. 2006, 23, 599–611. [Google Scholar] [CrossRef]
- Pinna, D.; Salvadori, O. Processes of biodeterioration: General mechanisms. In Plant Biology for Cultural Heritage. Biodeterioration and Conservation; Caneva, G., Nugari, M.P., Salvadori, O., Eds.; Getty Publications: Los Angeles, CA, USA, 2008. [Google Scholar]
- Li, T.; Hu, Y.; Zhang, B.; Yang, X. Role of Fungi in the Formation of Patinas on Feilaifeng Limestone, China. Microb. Ecol. 2018, 76, 352–361. [Google Scholar] [CrossRef] [PubMed]
- Trovão, J.; Tiago, I.; Catarino, L.; Gil, F.; Portugal, A. in vitro analyses of fungi and dolomitic limestone interactions: Bioreceptivity and biodeterioration assessment. Int. Biodeter. Biodegrad. 2020, 155, 105107. [Google Scholar] [CrossRef]






| Species | Strain ID 1,2 | Country | Substrate | GenBank Accession Number 3 | ||
|---|---|---|---|---|---|---|
| LSU | ITS | rpb2 | ||||
| Aeminium ludgeri | E8 | Portugal | Limestone | MG938284 | MG938056 | MG948613 |
| Aeminium ludgeri | E11 | Portugal | Limestone | MG938285 | MG938057 | MG948614 |
| Aeminium ludgeri | E12 | Portugal | Limestone | MG938286 | MG938054 | MG948615 |
| Aeminium ludgeri | E13 | Portugal | Limestone | MG938287 | MG938061 | MG948616 |
| Aeminium ludgeri | DSMZ 106916 T | Portugal | Limestone | MG938288 | MG938062 | MG948617 |
| Aeminium ludgeri | E15 | Portugal | Limestone | MG938289 | MG938063 | MG948618 |
| Aeminium ludgeri | E16 | Portugal | Limestone | MG938290 | MG938055 | MG948619 |
| Aeminium ludgeri | E17 | Portugal | Limestone | MG938291 | MG938058 | MG948620 |
| Aeminium ludgeri | E18 | Portugal | Limestone | MG938292 | MG938059 | MG948621 |
| Aeminium ludgeri | E19 | Portugal | Limestone | MG938293 | MG938060 | MG948622 |
| Amycosphaerella africana | CBS 110500 ET | Australia | Eucalyptus globulus | KF901837 | KF901516 | KF902223 |
| Capnodium gamsii | CBS 146153 | Thailand | Lagerstroemia speciosa | MN749168 | MN749238 | MN829263 |
| Chaetothyrina guttulata | MFLUCC15-1080 | Thailand | – | KU358917 | KX372277 | – |
| Chaetothyrina musarum | MFLUCC15-0383 | Thailand | – | KU710171 | KX372275 | – |
| Cladosporium cladosporioides | CBS 170.54 NT | UK, England | Arundo leaf | MH868815 | AY213640 | GU357790 |
| Cladosporium ramotenellum | ATCC 36970 | – | Populus tremuloides | MF951116 | MF951281 | MF951413 |
| Comminutispora agavaciensis | CBS 619.95 T | USA | Plant | EU981286 | MH862543 | MN829337 |
| Cystocoleus ebeneus | L161 | Austria | Rock sample | EU048578 | – | – |
| Cystocoleus ebeneus | L348 | Austria | Rock sample | EU048580 | – | – |
| Dissoconium aciculare | CBS 342.82 | Germany | – | EU019266 | AF173308 | – |
| Elsinoe phaseoli | CBS 165.31 | Cuba | Paseolus lunatus | DQ678095 | KX887263 | KX887144 |
| Exopassalora zambiae | CBS 112971 T | Zambia | Eucalyptus globulus | EU019273 | AY725523 | MF951421 |
| Extremus adstrictus | TRN 96 ET | Spain | Rock | KF310022 | AY559346 | KF310103 |
| Extremus antarcticus | CCFEE 5312 | Antarctica | Rock | KF310020 | KF309979 | KF310086 |
| Extremus antarcticus | CCFEE 451 | Antarctica | Sandstone | GU250360 | KF309978 | KF310085 |
| Leptoxyphium madagascariense | CBS 124766 T | Madagascar | Eucalyptus sp. | MH874923 | GQ303277 | MN829296 |
| Mycosphaerella sumatrensis | CBS 118502 | Indonesia | Eucalyptus sp. | KF901996 | JX901775 | KF902222 |
| Myriangium hispanicum | CBS 247.33 | – | Acer monspessulanum | KX887067 | MH855426 | GU371744 |
| Neodevriesia bulbillosa | CBS 118285 | Spain | Rock | KF310029 | AY559341 | KF310102 |
| Neodevriesia modesta | CCFEE 5672 ET | Italy | Rock | KF310026 | NR_144975 | KF310093 |
| Neodevriesiaceae sp. | CPC 19594 | Brazil | Mycoparasite | KJ564327 | – | KJ564349 |
| Neodevriesia queenslandica | CBS 129527 | Australia | Scaevola taccada | KF901839 | JF951148 | KF902234 |
| Neophaeotheca salicorniae | CBS 141299 | Africa | Salicornia meyeriana | MH878214 | KX228276 | MN829343 |
| Neophaeotheca triangularis | CBS 471.90 T | Belgium | Humidifier | NG057776 | – | MN829344 |
| Neophaeotheca triangularis | IHEM 5182 | Belgium | Humidifier | MH873909 | – | – |
| Parastagonospora nodorum | CBS 110109 | Denmark | Lolium perenne | EU754175 | KF251177 | KF252185 |
| Phaeotheca fissurella | CBS 520.89 T | Canada | Pinus contorta | MH873872 | MH862184 | MN829342 |
| Phragmocapnias betle | CPC 20476 | Philippines | Palm | MN749222 | MN749294 | MN829324 |
| Rachicladosporium americanum | CBS 124774 T | USA | Leaf litter | GQ303323 | GQ303292 | MN829336 |
| Rachicladosporium cboliae | CBS 125424 T | USA | Twig debris | MH875168 | GU214650 | LT799763 |
| Rachicladosporium eucalypti | CBS 138900 T | Ethiopia | Eucalyptus globulus | NG070537 | NR155718 | – |
| Rachicladosporium pini | CPC 16770 | Netherlands | Pinus monophylla | JF951165 | JF951145 | LT799764 |
| Racodium rupestre | L346 | Austria | Rock sample | EU048583 | GU067666 | – |
| Racodium rupestre | L424 | Italy | Rock sample | EU048582 | GU067669 | – |
| Ramularia endophylla | CBS 113265 ET | Netherlands | Quercus robur | KF902072 | KF901725 | KF902358 |
| Readeriella nontingens | CPC 14444 | Australia | Eucalyptus oblonga | KF902073 | KF901726 | KF902378 |
| Salinomyces thailandica | CBS 125423 | Thailand | Syzygium siamense | KF902125 | GU214637 | KF902206 |
| Saxispiralis lemnorum sp. nov. | MUM 23.14 | Portugal | Limestone | OR081765 | OR081767 | OR074926 |
| Saxispiralis lemnorum sp. nov. | MUM 23.15 | Portugal | Limestone | OR081766 | OR081768 | OR074927 |
| Schizothyrium pomi | CBS 486.50 | Netherlands | Polygonum sachalinense | KF902024 | – | KF902385 |
| Schizothyrium pomi | CBS 228.57 | Italy | – | KF902007 | – | KF902384 |
| Schizothyrium wisconsinense | OH49A1c | USA | Apple fruit | FJ147158 | FJ425209 | – |
| Teratosphaeria nubilosa | CBS 116005 | Australia | Eucalyptus globulus | KF902031 | KF901686 | KF902460 |
| Uwebraunia commune | CPC 830 ET | South Africa | Eucalyptus nitens | KJ564336 | – | KJ564351 |
| Uwebraunia dekkeri | CPC 13264 | Australia | Eucalyptus molucana | GQ852593 | – | KJ564340 |
| Xenodevriesia strelitziicola | CBS 122480 | South Africa | Strelitzia sp. | GU214417.1 | GU214635.1 | – |
| Analyses | Culture Medium | Composition * | Final pH | Positive Reaction | Reference |
|---|---|---|---|---|---|
| CaCO3 dissolution | CaCO3 Glucose Agar (CGA) | 5 g CaCO3, 5 g glucose, and 15 g agar in 1 L deionized water | 7 | Visualization of a clear zone around the colony | [87,88] |
| Calcium oxalate crystal formation | Modified Malt Extract Agar (MMA) | 33.6 g MEA and 5 g/L of CaCO3 in 1 L deionized water | 7 | Observation of calcium oxalate crystals under the light microscope | [88,89] |
| Other mineral precipitation | B4 | 10 g calcium acetate, 5 g yeast extract, 5 g glucose, and 15 g agar in 1 L deionized water | 8 | Observation of mineral precipitation (crystals) under the light microscope | [63,88,90] |
| Modified B4 (MB4) | Same recipe as B4 medium with substitution of calcium acetate for CaCO3 | 8 | |||
| HM 10% | 5 g yeast extract, 5 g casamino acids, 1 g Na-glutamate, 2 g KCl, 3 g Na3-citrate, 20 g MgSO4·7H2O, 100 g NaCl, 36 g FeCl2·4H2O, 0.36 mg MnCl2·4H2O, and 20 g agar in 1 L deionized water | 8 | |||
| pH alteration | Creatine Sucrose Agar (CREA) | 3 g creatine, 30 g sucrose, 1.3 g K2HPO4·3H2O, 0.5 g MgSO4·7H2O, 0.5 g KCl, 0.01 g FeSO4·7H2O, 0.01 g ZnSO4·7H2O, 0.005 g CuSO4·5H2O, 0.05 g Bromocresol purple, and 15 g agar in 1 L deionized water | 8 | Visualization of a yellow halo around the colony | [88,91] |
| Saxispiralis lemnorum gen. et sp. nov. Isolates | Acid Production | CaCO3 Dissolution | Calcium Oxalate Crystal Formation | Other Mineral Precipitation | ||
|---|---|---|---|---|---|---|
| CREA 1 | CGA 1 | MMA 1 | B4 1 | MB4 1 | HM10% 1 | |
| MUM 23.14 | − | − | − | + | − | + |
| MUM 23.15 | − | − | − | + | − | + |
Disclaimer/Publisher’s Note: The statements, opinions and data contained in all publications are solely those of the individual author(s) and contributor(s) and not of MDPI and/or the editor(s). MDPI and/or the editor(s) disclaim responsibility for any injury to people or property resulting from any ideas, methods, instructions or products referred to in the content. |
© 2023 by the authors. Licensee MDPI, Basel, Switzerland. This article is an open access article distributed under the terms and conditions of the Creative Commons Attribution (CC BY) license (https://creativecommons.org/licenses/by/4.0/).
Share and Cite
Paiva, D.S.; Trovão, J.; Fernandes, L.; Mesquita, N.; Tiago, I.; Portugal, A. Expanding the Microcolonial Black Fungi Aeminiaceae Family: Saxispiralis lemnorum gen. et sp. nov. (Mycosphaerellales), Isolated from Deteriorated Limestone in the Lemos Pantheon, Portugal. J. Fungi 2023, 9, 916. https://doi.org/10.3390/jof9090916
Paiva DS, Trovão J, Fernandes L, Mesquita N, Tiago I, Portugal A. Expanding the Microcolonial Black Fungi Aeminiaceae Family: Saxispiralis lemnorum gen. et sp. nov. (Mycosphaerellales), Isolated from Deteriorated Limestone in the Lemos Pantheon, Portugal. Journal of Fungi. 2023; 9(9):916. https://doi.org/10.3390/jof9090916
Chicago/Turabian StylePaiva, Diana S., João Trovão, Luís Fernandes, Nuno Mesquita, Igor Tiago, and António Portugal. 2023. "Expanding the Microcolonial Black Fungi Aeminiaceae Family: Saxispiralis lemnorum gen. et sp. nov. (Mycosphaerellales), Isolated from Deteriorated Limestone in the Lemos Pantheon, Portugal" Journal of Fungi 9, no. 9: 916. https://doi.org/10.3390/jof9090916
APA StylePaiva, D. S., Trovão, J., Fernandes, L., Mesquita, N., Tiago, I., & Portugal, A. (2023). Expanding the Microcolonial Black Fungi Aeminiaceae Family: Saxispiralis lemnorum gen. et sp. nov. (Mycosphaerellales), Isolated from Deteriorated Limestone in the Lemos Pantheon, Portugal. Journal of Fungi, 9(9), 916. https://doi.org/10.3390/jof9090916









